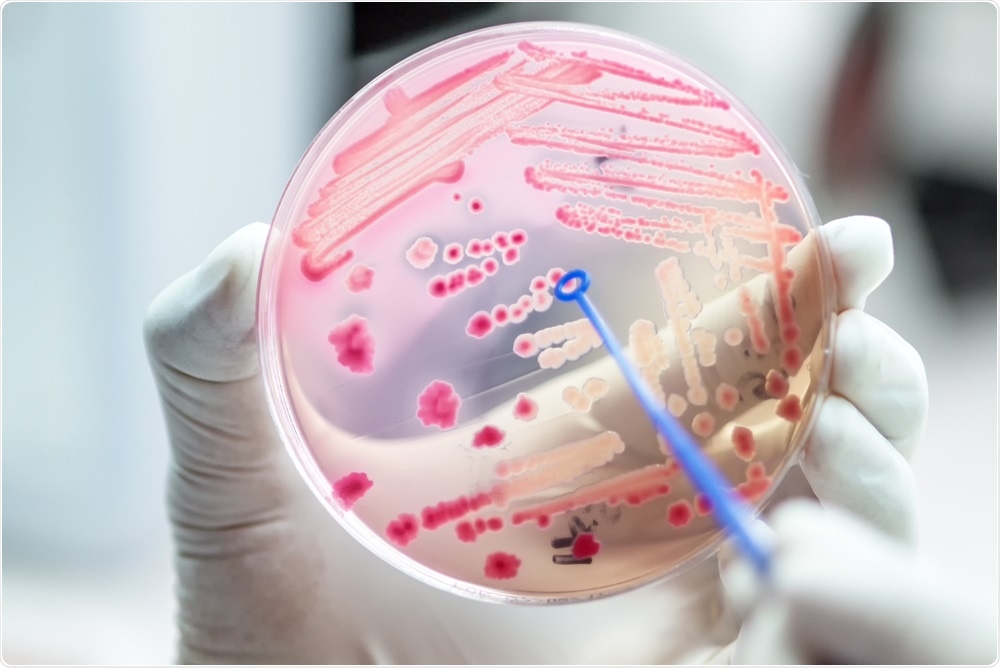
Antibiotic resistant bacteria on agar plate - diagnosis

An interview with Arlene Brailey from Antibiotic Research UK, discussing the impact of antibiotic-resistant infections on everyday life and the steps that need to be taken to overcome this issue.
Why is antibiotic resistance considered to be a global health threat?
The use of the word ‘global’, indicates that it is a worldwide problem. The widespread availability of affordable flights has meant that thousands of people are able to travel around the world, and the bacteria they are carrying travel too.
We have seen this clearly demonstrated through the coronavirus pandemic – and bacteria are no different. On top of this, the bacteria we are carrying are sometimes resistant strains that do not respond to the antibiotics we already have.
 Image Credit: Ratchawat Nick Wanichakul / Shutterstock.com
Image Credit: Ratchawat Nick Wanichakul / Shutterstock.com
No country is immune from this problem, and no single country has the power to stop it from occurring. The World Health Organization estimates that 10 million people will die of antibiotic-resistant infections by 2050, and figures released this year show that drug-resistant infections have risen by about 9% in the last year.
If we do not solve this problem, we will return to an age where people die from something as simple as a cut or scratch, and routine operations such as hip replacements must be cancelled as the risk is too high.
This is why we call it a global health threat.
Why is the search for new antibiotics a big challenge for the pharmaceutical industry?
The pharmaceutical industry is governed by the market and they need to make a profit. The bottom line is that there is simply no real profit in developing antibiotics anymore. The reason for this is because when a powerful new antibiotic is developed, it is saved for those rarer occasions where bacterial resistance has already developed to every other antibiotic.
Unlike medications used for chronic illness, where companies make a profit from their long-term use, antibiotics are the opposite.
Some small pharmaceutical companies have actually gone out of business when they have tried to develop an antibiotic because they can’t recuperate the cost of development once the drug goes to market.
The model just does not work. To solve this, we need to somehow incentivize pharmaceutical companies to use a different financial model to develop new antibiotics.
How is Antibiotic Research UK working to reduce the prevalence of antibiotic-resistant infections?
As a charity, our aim is to beat the world’s biggest health problem; antibiotic resistance. We believe we deliver remarkably good value for money in terms of the research programs that we fund.
We are tackling antibiotic resistance from all angles. We work with academic researchers to develop discovery programs, and we are also the leading campaigner in the media about antibiotic resistance.
Working with our partners, we have encouraged a shift in the way that patients see antibiotics.
We are educating patients about the issue to prevent them from demanding antibiotics and educating healthcare professionals about good stewardship of the precious antibiotics we have remaining.
We also support patients with recurring or resistant infections through our patient support program, which is the first of its kind. The program aims to support patients and their families who are living with resistant infections and the challenges that this brings to their daily lives.
Why was Antibiotic Research UK created and what is the vision for the charity?
The charity was created to bring experts together to try and find alternatives to current antibiotics and prevent the apocalyptic situation that WHO has predicted. We bring scientists and clinicians together to share their expertise and see what we can achieve together.
There are three elements to our vision. The first is scientific discovery; new antibiotics, new combinations of antibiotics, and even new antimicrobial treatments that offer an alternative to antibiotics. We have already shown success with a non-antibiotic treatment that we developed against travelers’ diarrhea.
The second part of our vision is about improving health literacy for the public and healthcare professionals in relation to antibiotic resistance.
We educate people about antibiotic resistance and how to prevent it. The final element is our patient support program, which provides reliable information and support to patients and their families at a time when they can feel incredibly isolated.
Image Credit: Sirirat / Shutterstock.com
Image Credit: Sirirat / Shutterstock.com
At BioInfect 2020, you presented a talk on the impact of antibiotic-resistant infections on patients. Please can you tell us about the case studies you presented?
BioInfect welcomed a group of professionals from various industries, all focused on solving the issue of antibiotic resistance. As the representative for Antibiotic Research UK, I felt it was my role to impress upon these individuals just how important research and development is for patients.
I described the experiences of five patients with infections resistant to antibiotics and the impact that their condition has on everyday life. It is easy to lose sight of the patient at the end of the research, so I wanted to remind all of the important stakeholders at the conference that there are patients desperately waiting for a new antibiotic or new combination treatment to be found.
Through all of the stories that I told, the aim was to explain that every patient is hoping that somebody is going to do something to make the future better, both for themselves and for the patients emerging after them with resistant bacterial infections. One of the things that encourage patients most is knowing that this research is happening, and new drugs are actually being developed and tested.
It is also important for them to know that scientists, clinicians, and those working in the pharmaceutical industry are coming together to try and solve the problem at conferences like this. Often, patients never hear about these types of events and they feel hopeless and fear for their future.
How does the charity support patients who are suffering from antibiotic-resistant infections and their families?
This is a project that has been building up over the past year. We have been developing a whole raft of measures to support patients and their families, but the most important part of my role is listening to patients describe what they are living through and dealing with.
Many of these patients feel incredibly isolated. Sadly, the impact of antibiotic resistance on everyday life is not well-publicized so patients’ friends, colleagues, and families struggle to understand or empathize.
For example, they may have to cancel a day out with their friends because they feel so fatigued or feverish, or just listless. These friends may see them a couple of days later and they appear fine, giving the impression that they made an excuse.
I myself have experienced the effects of chronic illness within my own family, and as a carer, you often feel quite helpless and alone. I have been through the frustration of not being able to get an accurate diagnosis or treatment for that family member.
This is compounded by the fact that information available online is highly variable and rarely trustworthy, and there is a distinct lack of reliable forums for patients going through the same struggles with infection.
When I talk to patients, I listen and try to distill the story. Often, they have questions that they can’t find the answers to, or they have been given misinformation online. When we get to that point, I help them to outline the main issues, provide informative leaflets or web information that we have created, or signpost them to other sources of help.
We have leaflets on managing infections with specific bacteria and even guides for those who are living with resistant bacteria such as ESBL E. coli, a common source of antibiotic-resistant urinary tract infections (UTIs).
We have built sections of the website around certain conditions where we know there is a lack of reliable information available online, for example, resistant skin and soft tissue infections, and we are adding to this all the time.
The other aspect that I have been heavily involved in is allowing patients to write down their experiences and share them on our website. Most of these patients are happy to include their names and a photograph, but others want to remain anonymous because they feel there is still a stigma around carrying an antibiotic-resistant infection.
This is despite the fact that many of the population actually carry around resistant bacteria in their bodies without realizing and without it causing them any illness.
Sharing their experiences and perspective helps to show other people with similar conditions that they are not alone. This has now expanded into me trying to connect patients with one another. I mediate the calls because these patients are vulnerable, and we have to be sensitive about that, but it is an opportunity for people with similar conditions to talk to each other.
Further to this, I am now in the process of starting up an online patient support forum. I am not sure about the form that it will take but the aim is to provide comfort, support, and practical help that others in a similar situation can provide to one another.
Aside from new antibiotics, what other steps need to be taken to overcome the issue of antibiotic resistance?
Firstly, we need to increase the speed at which we discover new antibiotics and new combinations. We must instill a sense of urgency in industry and academia rather than the pace that we are currently working at. Work has begun, but it’s not fast enough or effective enough for the scale of the problem that we are facing.
We also need to do more to raise awareness globally amongst healthcare professionals as well as the public. One way of doing this is to educate the children of today about basic things like hand hygiene and the most effective ways of preventing the spread of antibiotic resistance.
The coronavirus pandemic has emphasized the importance of hand washing and hopefully, these lessons will remain with children and adults alike beyond this outbreak.
They also need to understand how bacteria become resistant and why it is a problem. If we include all of this in educational programs, we can have a real impact on the prevalence of antibiotic resistance. However, we need the support of the government to do this.
Beyond education, we need to make antibiotic resistance everybody’s responsibility, from carers in the community to patients going to their local GP and nurses working in care homes. Most people assume that hygiene is only important in hospitals, but it’s just as important in the community.
Learning to wash our hands after turning all the door handles on the way to work, for example, is essential. We need to educate everybody to reduce the spread of infection as well as becoming good stewards of the antibiotics that we have so that they are used sparingly but appropriately and effectively.
 Image Credit: Kateryna Kon / Shutterstock.com
Image Credit: Kateryna Kon / Shutterstock.com
With all of these measures, plus new antibiotics, do you think we can reduce the number of antibiotic-resistant infections?
This is a multifaceted problem. At this moment in time, we can prevent death from severe infections but until we develop new antibiotics and new treatments, we cannot be sure that the patient will survive. We need a whole societal approach to this on a global level.
The government needs to incentivize pharmaceutical companies to develop new antibiotics because it’s not happening right now.
There are other facets as well, such as agriculture and farming. This industry needs to take responsibility for the antibiotics that they use every day.
Finally, there are the public-facing campaigns. There are now posters and campaigns happening in community pharmacies and doctor’s surgery to explain to patients that if they have the ‘flu or a cold, they do not need an antibiotic. We need to somehow enlarge that message and widen our reach.
I am currently working on a pilot project with Public Health England that's tackling antibiotic resistance in 150 community pharmacies. As part of the project, pharmacists are encouraged to speak to every patient who is receiving a prescription for antibiotics.
A member of the community pharmacy team will have an informal conversation about the risk of antibiotic resistance and the importance of finishing a course of antibiotics, for example. I am providing support by offering leaflets about Antibiotic Research UK and our Patient Support role in these locations to support this conversation.
What do the next few years look like for Antibiotic Research UK?
In terms of patient support, I think I'm only going to hear from more and more patients as the number of cases of antibiotic-resistant infections continues to rise. I would like to raise awareness of the support that we can offer because, at the moment, the only way I can reach patients is if they come across our website or if they are put in touch with us through a health care professional.
I hope that alongside the work that I do, a nationwide support system will also be developed by Antibiotic Research UK. I would love to see this grow into local groups around the country where people can support one another. Further to this, I would like to see more reliable information online about antibiotic resistance.
On the side of research and development, my goal is to continue sharing the work that Antibiotic Research UK does and the partnerships that we set up.
Underpinning all of this is the donations that we receive. We are a charity, and to provide these services we need funding and investment. Developing new antibiotics needs huge investment, and the solution to that is difficult. However, I think if we don't get our act together as a nation and globally, it will cost countless lives.
One lesson from the coronavirus outbreak is that we cannot wait until it happens to deal with the issue. We need to act now and have new antibiotics and treatments ready and available before that day arrives and antibiotic resistance costs more and more lives on an even larger scale than coronavirus.
What can our readers do to support the work of Antibiotic Research UK?
Antibiotic Research UK relies entirely on charitable donations to fund our work. If you would like to support our work you can:
- Donate directly through our website,
- Hold a fundraising event,
- Take part in a sporting challenge to raise money for us,
- Support us through your company,
- Remember us in your will
- Volunteer to become a Community Ambassador
- Become a member.
For more information visit: https://www.antibioticresearch.org.uk/support-us/
Where can our readers find more information?
About Arlene Brailey
 As a pharmacist with over 20 years’ experience in postgraduate education in my previous post as Assistant Director of NHS Education for Scotland (Pharmacy), I have experience in a wide variety of national projects involving the gathering and sharing of information. Examples include the introduction of both distance learning and web-based educational programs for 4500 Pharmacists across Scotland. Many of the programs I produced were adopted by or co-produced with other countries within the UK.
As a pharmacist with over 20 years’ experience in postgraduate education in my previous post as Assistant Director of NHS Education for Scotland (Pharmacy), I have experience in a wide variety of national projects involving the gathering and sharing of information. Examples include the introduction of both distance learning and web-based educational programs for 4500 Pharmacists across Scotland. Many of the programs I produced were adopted by or co-produced with other countries within the UK.
My work evolved into the field of antimicrobial stewardship when I served for approx 8 years as the Education Lead within the Scottish Antimicrobial Prescribing Group (SAPG). This included the production of educational resources around antimicrobial stewardship for Pharmacists, Nurses, General Medical Practitioners, and Foundation Year doctors.
I hope my experience of working in this field, and an understanding of the complex issues around antimicrobial stewardship and antimicrobial resistance will help me to serve and support both patients and the wider goals of ANTRUK.
Arlene’s position as a Patient Support Officer is the first such position in the UK to be funded by a charity. On a personal note, Arlene is a carer for her 24-year-old son who has been unwell with resistant infections for over 6 years.
About Antibiotic Research UK
Antibiotic Research UK was founded in 2014 to tackle antibiotic resistance. They are a ‘virtual’ charity, which means that they do not have a central office, which allows them to spend more of your donation on research into new antibiotics, rather than paying overheads, and allows world-class experts to be an integral part of their work, wherever they are based.
The charity aims to raise sufficient funds over the next five years to bring at least one new antibiotic treatment to market by the early 2020s. The research they fund will be carried out by universities and businesses in the UK and overseen by the antibiotic-resistance experts that make up their Science Committee.
Antibiotic Research UK also aims to provide public and professional education and information for patients. The charity is seeking to raise a further £5 million by 2021. Since the charity’s formation, it has raised over £1 million, with year-on-year growth of at least 30%.
Produced in partnership with Bionow
This interview took place at the Bionow BioInfect conference in February 2020. For more conferences and events like this, visit the Bionow website.
.jpg)